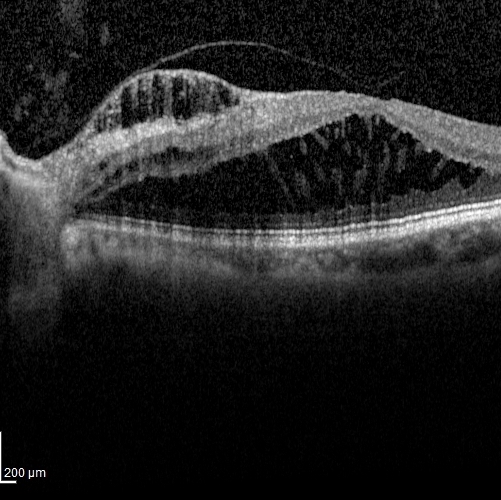
onpit

Academic Courses
Services
-
Student Performace Committee 2014 - 2018, Chair 2017 - 2018
Purpose - The College’s Student Performance Committee reviews the overall academic progress of each student enrolled in the college and considers violations of the Standards of Professional Conduct when requested by the respective College Dean. These standards and the operation of the college’s Student Performance Committee are contained in the appropriate Program Specific section of this Catalog: Two Major contributions:
Development and implementation of flowsheets to govern daily academic operations of the committee
Finalization of Conduct hearing scropts with University Legal Council
-
Advanced Technology Partnership Committee 2014 - Present
The Academic Technology Partnership (ATP), which was formed in July 2010, is a collaboration of the Office of Academic Affairs and Office of Information Technology (IT). This working group was created to identify, develop, prioritize, and address technology needs for academic programs at Western University of Health Sciences. The membership consists of faculty representatives from each of the 9 Colleges (appointed by each College Dean), and the Executive Director of Information Technology serves as Co-Chair with one of the appointed faculty members.
The goal of the Partnership is to serve faculty users, encourage communication, provide professional development and apply the potential of academic technologies to the college curricula, in an effective and cost efficient manner. Here is the link with details
-
Academic Senate 2017 - 2018
The Academic Senate is a representative committee of the Academic Assembly. In discharging this function, the Academic Senate has the authority to conduct studies, make reports and recommendations on all matters which have a significant bearing on the work of this faculty. The Academic Senate is a channel of communication between the Academic Assembly and administration of the University. Here is the link with details
-
Academic Support Services and Planning Committee 2016 -Present, Co-Chair 2017 - 2018
The committee is responsible for periodically reviewing existing policies and providing guidance, as a representative body of the Academic Senate, and faculty input to Information Technology, Library, Research, Human Resources, Facilities and other co-curricular and support services departments. The committee is also responsible for reviewing and approving co-curricular policies that impact quality of curriculum and the ability of the faculty to perform their duties. The committee is also responsible for participating in program review processes, as well as that of all co-curricular and support-services departments. The committee shall participate in university strategic planning and other planning processes within the various support services units. Finally, the committee shall serve as the primary channel of communication between support service units and the academic senate. Here are the details
-
Evidence Based Optometry Committee 2014 - 2018
The Institute of Medicine (IOM), a division of the National Academies of Sciences, Engineering, and Medicine, at the request of the U.S. Congress in 2008, was asked to undertake a study on the best methods for the development of trustworthy clinical practice guidelines. These methods would address the structure, process, reporting, and final products of systematic reviews of comparative effectiveness research and evidence-based clinical practice guidelines. In 2010, in anticipation of these changes, a sub-group of the AOA Quality Improvement Committee was asked to investigate and initiate an evidence-based guideline development pilot project. Due to the importance and magnitude of this work, the AOA Board of Trustees appointed Evidence-Based Optometry (EBO) as a stand-alone committee in 2012.
The EBO Committee has worked diligently to create an evidence-based process that aligns with the NAM standards and keeps optometrists in the forefront of evidence-based practice. -
Accreditation Council on Optometric Education (ACOE) Consultant 2016 - 2018
The Accreditation Council on Optometric Education (ACOE) is the only accrediting body for professional optometric degree (O.D.) programs, optometric residency programs and optometric technician programs in the United States and Canada. Both the U.S. Department of Education and the Council on Higher Education Accreditation recognize the ACOE as a reliable authority concerning the quality of education of the programs the Council accredits. ACOE accreditation means the programs that have attained accredited status:
Meet the Council's standards of educational effectiveness; and
Show a demonstrated commitment to quality assessment and improvement.
-
Society of Science Member and ISEF Judge 2017
The Intel International Science and Engineering Fair (Intel ISEF), a program of Society for Science & the Public (the Society), is the world’s largest international pre-college science competition.
California State: Toxicology Junior division Judge: 2017
ISEF Bioemedical and Health Sciences Judging: 2017
Research, Publications and Presentations
Select Publications

Effect of inferior-segment Intacs with and without C3-R on Keratoconus
J CATARACT REFRACT SURG - VOL 33, JANUARY 2007
Here is link from ScienceDirect

Adjustable Suture Strabismus Surgery in infants and children
J AAPOS 2008;12:585-590
Here is link for free download from AAPOS

Higher Order Aberrations and Relative Risk of Symptoms After LASIK
J Refract Surg. 2007;23:252-256.
Here is Pubmed link

Comparison of Single-Segment and Double-Segment Intacs for Keratoconus and Post-LASIK Ectasia
Am J Ophthalmol 2006;141: 891–895
Here is Pubmed Link
Publications and Posters
1. Fahim, NM, Sharma M Anatomical Explanation of Optic Disc Pit Maculopathy Associated with Good Visual Acuity Poster Presentation at Annual Optometry’s Meeting 2017 at Washington, DC.
2. Sharma M, Pham C, Gordon RL, Sharma G Case report describing management of recurrent corneal erosion secondary to Filamentary Keratitis with dried amniotic extracellular matrix. Poster Presentation at American Academy of Optometry Annual Meeting 2016 at Anaheim, CA.
3. Van K, Yumori J, Sharma M, Jakirlic N, Ballas L Lymphoma of MALT in a case of Chronic Conjunctivitis. Poster Presentation at American Academy of Optometry Annual Meeting 2016 at Anaheim, CA.
4. Sharma M, Gordon, RL Case Report of Keractoconus associated with Melnick Needles Syndrome. Poster Presentation at American Academy of Optometry Annual Meeting 2015 at New Orleans, LA.
5. Sharma M, Sharma G Evaluation of clinical response to treatment with FDA-cleared Avenova (i-Lid Cleanser) in patients with blepharitis in an optometric practice. Poster Presentation at the Association for Research in Vision and Ophthalmology Annual Meeting 2015 at Denver, CO.
6. Sharma M, Davey PG, Maeda R. Case series describing Retinal Manifestations along with OCT findings amongst patients of Fabry Disease. Poster Presentation at The American Optometric Association Annual Meeting 2015 at Seattle, WA.
7. Nehmad L, Yang A, Sharma M. A Comparative Study of Methods used to evaluate Visual field Progression in Glaucoma Poster Presentation at American Academy of Optometry Annual Meeting 2013 at Seattle, WA.
8. Sharma M, Bass S, Chirumbolo A. Case of concurrent CME and Primary Open Angle Glaucoma responding positively to single medication: Topical Carbonic Anhydrase Inhibitors at American Academy of Optometry Annual Meeting 2013 at Seattle, WA.
9. Awadein A, Sharma M, Bazemore MG, Saeed HA, Guyton DL. Adjustable Suture Strabismus Surgery in infants and children J AAPOS. 2008 Dec;12(6):585-90
10. Sharma M, Boxer Wachler BS, Chan CC. Higher Order Aberrations and Relative Risk of Symptoms After LASIK. Journal of Refractive Surgery. 2007 Mar;23(3):252-6.
11. Chan CC, Sharma M, Boxer Wachler BS. Effect of inferior-segment Intacs with and without C3-R on keratoconus. J Cataract Refract Surg. 2007 Jan;33(1):75-80.
12. Sharma M, Boxer Wachler BS. Comparison of single-segment and double-segment Intacs for keratoconus and post-LASIK ectasia. American Journal of Ophthalmology. 2006 May;141(5):891-5.
13. Sharma M, Boxer Wachler BS. Intacs for Keratoconus and Lasik-Induced Ectasia. Techniques in Ophthalmology. 2004 Dec;2(4):137-141.
14. Sharma M, Guyton DL. Poster Presentation: Removable noose in adjustable surgery in strabismus. American Academy of Pediatric Ophthalmology and Strabismus Annual Meeting, 3/2006.
15. Sharma M, Guyton DL. Paper: Adjustable muscle surgery in pediatric patients. International Strabismological Association in São Paulo, Brazil, 2/2006.
16. Sharma M, Boxer Wachler BS. Paper: Corneal collagen crosslinking with riboflavin increases effect (lower L-U ratio) of single segment Intacs in post-lasik ectasia and keratoconus. American Academy of Ophthalmology Annual Meeting, 10/2005.
17. Sharma M, Boxer Wachler BS. Paper: Corneal collagen crosslinking with riboflavin for corneal stabilization. American Academy of Ophthalmology Annual Meeting, 10/2005.
18. Sharma M, Boxer Wachler BS. Paper: Establishing thresholds of post-LASIK induced aberrations in symptomatic patients. American Society of Cataract and Refractive Surgery Annual Meeting, 4/2005.
19. Sharma M, Boxer Wachler BS. Paper: Technique for bilateral simultaneous Verisyse lens implantations. American Society of Cataract and Refractive Surgery Annual Meeting, 4/2005.
20. Sharma M, Boxer Wachler BS. Paper: Treatment protocol for LASIK-induced ectasia. American Society of Cataract and Refractive Surgery Annual Meeting, 4/2005.
21. Sharma M, Boxer Wachler BS, Chao L. Paper: Intacs for keratoconus. American Society of Cataract and Refractive Surgery Annual Meeting, 4/2005.
22. Panda A, Sharma M, Madhavi P. Poster Presentation: Yet another therapy for the management of acute Hydrops. All India Ophthalmic Society Annual Meeting, 1/2004.
Invited Speaker/CE Talks
• Lasers in Eye Care: IEOS Feb 2017
• Asian American Optometry Society “Bilateral Proptosis” May 2016
• Webinar “Ocular Findings in Children with Abusive Head Trauma” March 2016
• CE Talk “Adaptive Optics” Okularfest 2015
• Webinar “Advances in Retina Diagnosis and Management” June 2015
• CE Talk “Cataract Surgery Co-Management” for Luxotica Optomterist Association June 2015
• OMNI New York CE 2014 Retinal Grand Rounds
• Bergen Passaic Society of Optometric Physicians 2014, Idiopathic Orbital Inflammatory Syndrome
• Bergen Passaic Society of Optometric Physicians 2013, Retina Grand Rounds
• Hudson Valley Optometric Society 2013, Advances in AMD
• OMNI CE Event 2013, Adaptive Optics.
Research Trials
• Investigator: Effective Sideline Concussion Screening Technique for High School Football Players.
• Co-Investigator: Maestro 4 Topcon Normative Database study for FDA approval Jan 2015- completion
• Co-Investigator in IRB approved clinical study on “Adjustable muscle surgery in pediatric patients9” at Wilmer Eye Institute at Johns Hopkins University Medical Institution, Baltimore, MD 2006
• Co-Investigator in clinical study “Comparison of single-segment and double-segment Intacs for keratoconus and post-LASIK ectasia6.” at Boxer Wachler Vision Institute, Beverly Hills, CA 2005
• Co-Investigator in clinical study “Effect of inferior-segment Intacs with and without C3-R on keratoconus5” at Boxer Wachler Vision Institute, Beverly Hills, CA 2005
• Co-Investigator in clinical study “Intacs for Keratoconus and Lasik-Induced Ectasia.5,7,10,11” at Boxer Wachler Vision Institute, Beverly Hills, CA 2005
Technology

Safesidelines.com
Service Project for sideline concussion screening for the Pomona Unified School District